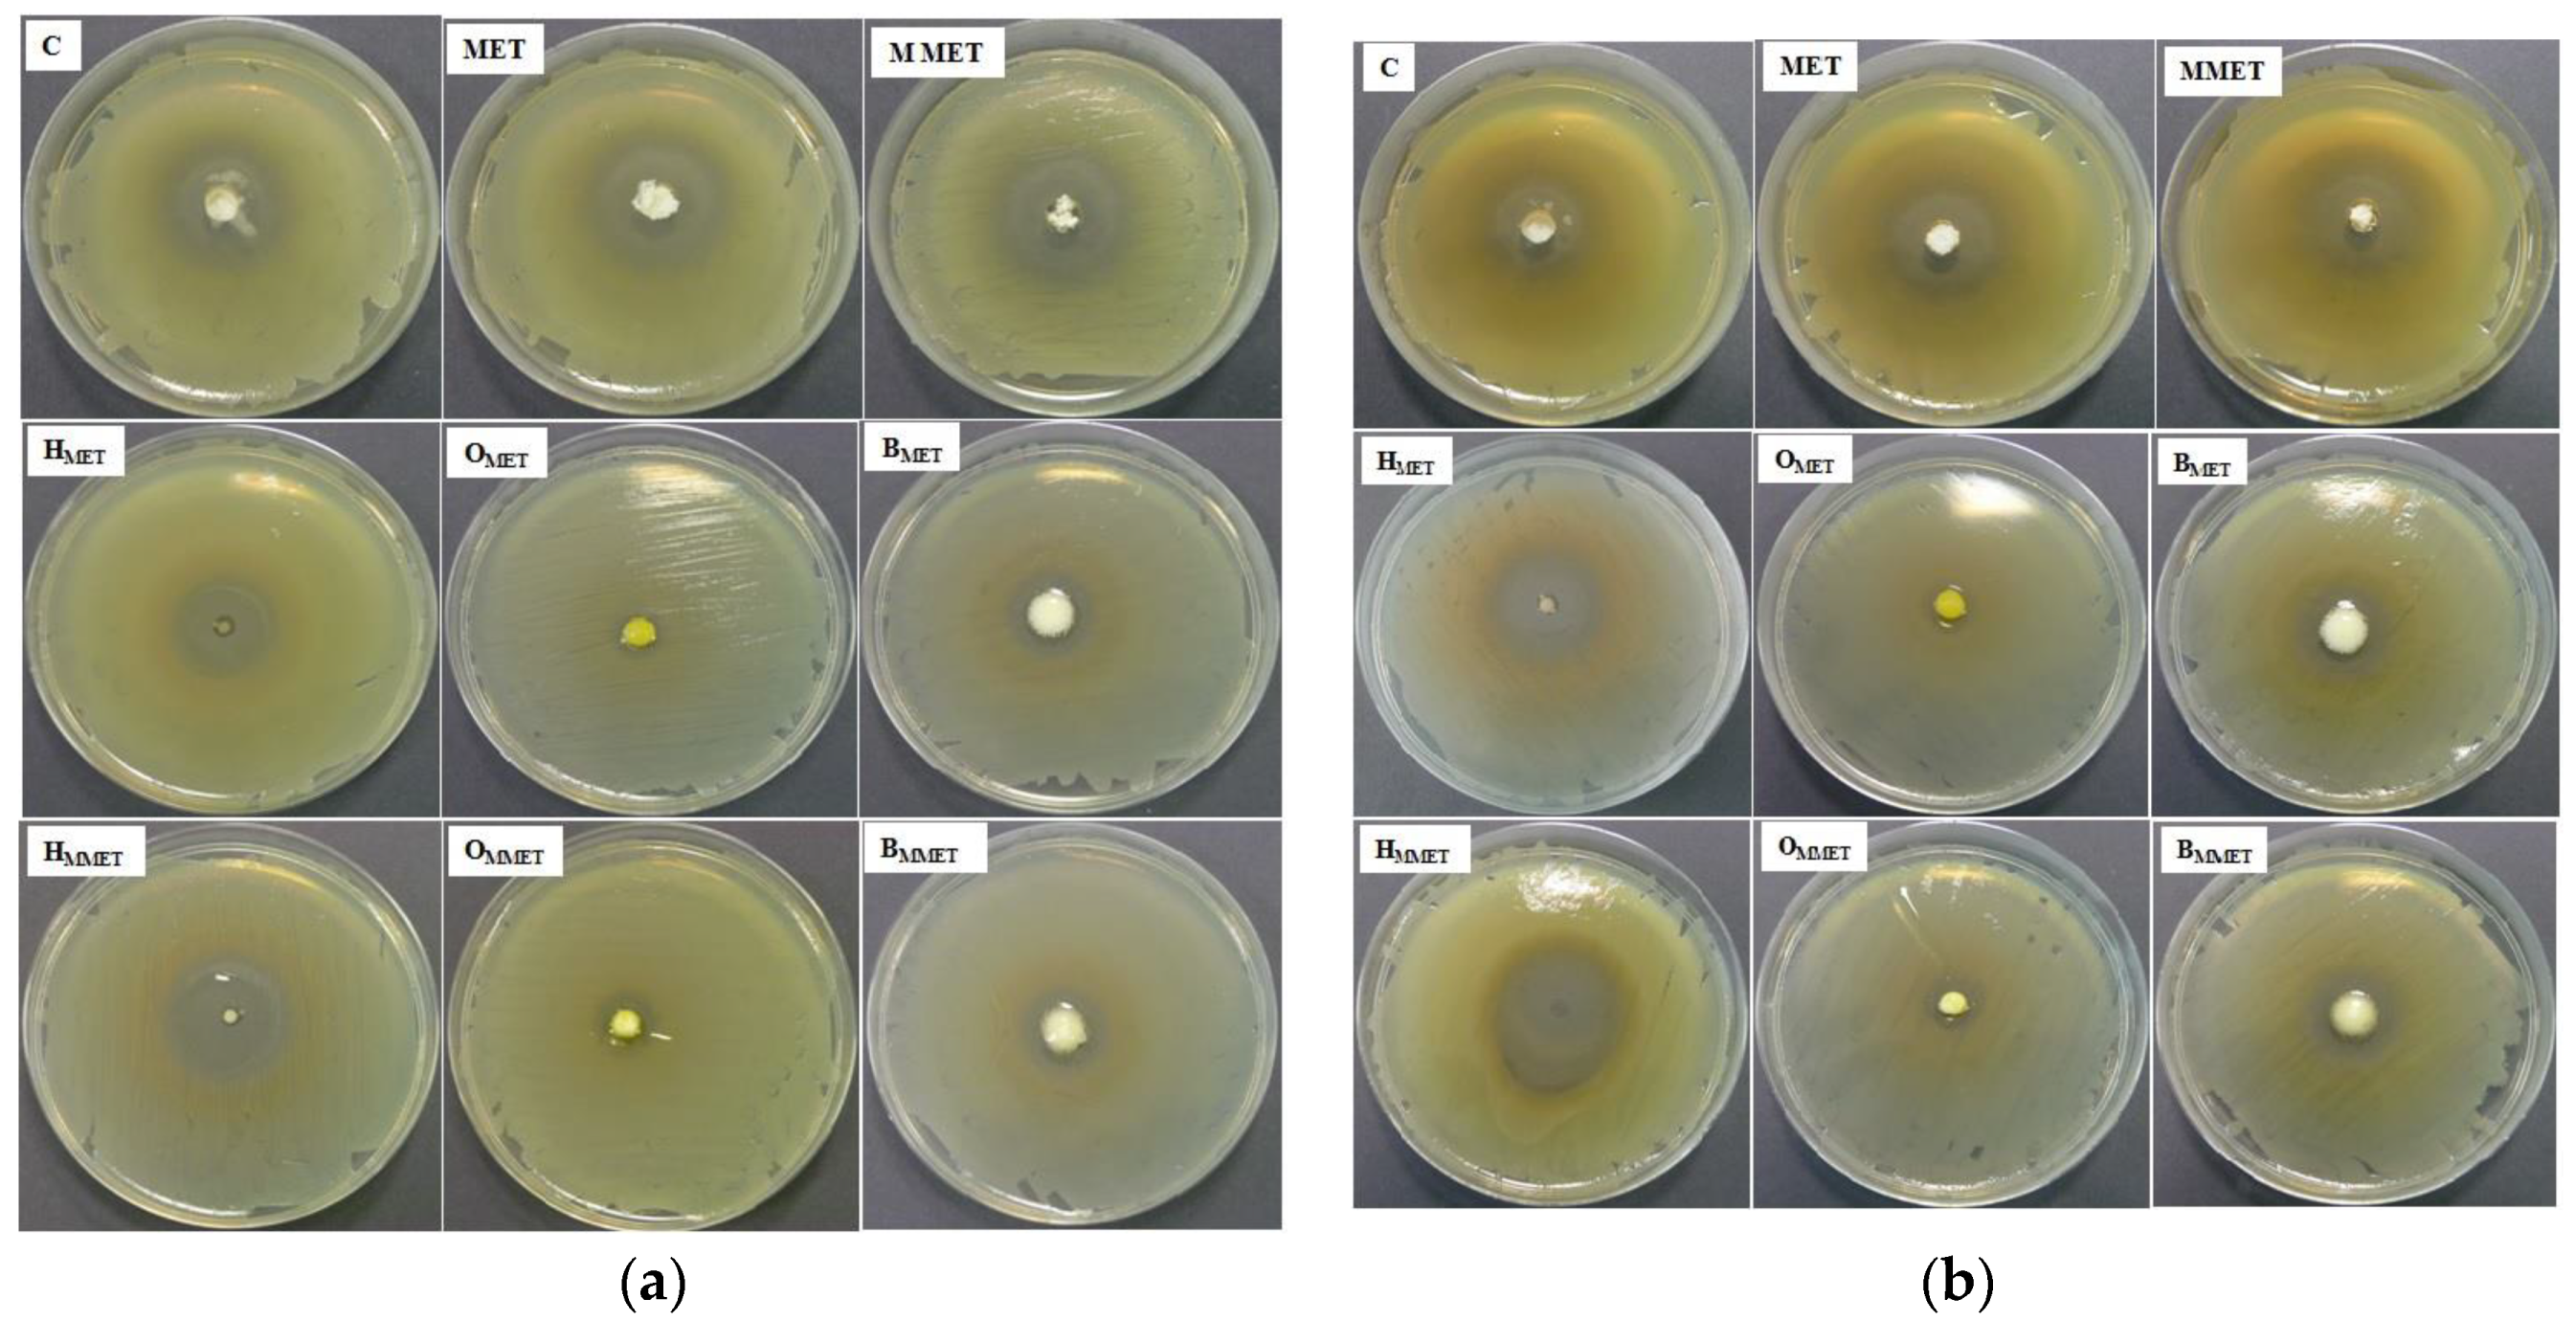

Different Types of Gel Carriers as Metronidazole Delivery Systems to the Oral Mucosa
Abstract
1. Introduction
2. Materials and Methods
2.1. Materials
2.2. Preparation and Characterization of MET
2.2.1. Micronization of MET
2.2.2. DSC Analysis
2.2.3. Solubility Studies
2.3. Preparation and Physicochemical Characteristics of Hydrogels, Oleogels and Bigels
2.3.1. Preparation of Hydrogels, Oleogels and Bigels
2.3.2. Drug Content Analysis by HPLC Method
2.3.3. pH Determination
2.3.4. Particle Size Analysis
2.3.5. Viscosity Measurement and Determination of Rheological Properties
2.3.6. Texture Analysis
2.4. Ex Vivo Bioadhesive Properties
2.5. In Vitro Release
Mathematical Modeling of the Drug Release
2.6. Antimicrobial Activity
2.7. Ex Vivo Permeation Study
2.8. Statistical Analysis
3. Results and Discussion
3.1. Micronization of MET
3.2. Preparation and Physicochemical Characteristics of Hydrogels, Oleogels and Bigels
3.3. Ex Vivo Bioadhesive Properties
3.4. In Vitro Release
3.5. Antimicrobial Activity
3.6. Ex Vivo Permeation Study
4. Conclusions
Author Contributions
Funding
Acknowledgments
Conflicts of Interest
References
- Jin, L.J.; Lamster, I.B.; Greenspan, J.S.; Pitts, N.B.; Scully, C.; Warnakulasuriya, S. Global burden of oral diseases: Emerging concepts, management and interplay with systemic health. Oral Dis. 2016, 22, 609–619. [Google Scholar] [CrossRef]
- Tonetti, M.S.; Jepsen, S.; Jin, L.; Otomo-Corgel, J. Impact of the global burden of periodontal diseases on health, nutrition and wellbeing of mankind: A call for global action. J. Clin. Periodontol. 2017, 44, 456–462. [Google Scholar] [CrossRef]
- Nazir, M.A. Prevalence of periodontal disease, its association with systemic diseases and prevention. Int. J. Health Sci. 2017, 11, 72–80. [Google Scholar]
- How, K.Y.; Song, K.P.; Chan, K.G. Porphyromonas gingivalis: An overview of periodontopathic pathogen below the gum line. Front. Microbiol. 2016, 7, 53. [Google Scholar] [CrossRef]
- Casarin, M.; Pazinatto, J.; Santos, R.C.; Zanatta, F.B. Melaleuca alternifolia and its application against dental plaque and periodontal diseases: A systematic review. Phytother. Res. 2018, 32, 230–242. [Google Scholar] [CrossRef]
- Graziani, F.; Karapetsa, D.; Alonso, B.; Herrera, D. Nonsurgical and surgical treatment of periodontitis: How many options for one disease? Periodontology 2000 2017, 75, 152–188. [Google Scholar] [CrossRef]
- Hamed, R.; AbuRezeq, A.; Tarawneh, O. Development of hydrogels, oleogels, and bigels as local drug delivery systems for periodontitis. Drug Dev. Ind. Pharm. 2018, 44, 1488–1497. [Google Scholar] [CrossRef]
- Nguyen, S.; Hiorth, M. Advanced drug delivery systems for local treatment of the oral cavity. Ther. Deliv. 2015, 6, 595–608. [Google Scholar] [CrossRef]
- Bansala, M.; Mittala, N.; Yadavb, S.K.; Khanb, G.; Guptac, P.; Mishrab, B.; Nathc, G. Periodontal thermoresponsive, mucoadhesive dual antimicrobial loaded in-situ gel for the treatment of periodontal disease: Preparation, in-vitro characterization and antimicrobial study. J. Oral Biol. Craniofac. Res. 2018, 8, 126–133. [Google Scholar] [CrossRef]
- Léber, A.M.; Urbán, E.; Vályi, P.; Gácsi, A.; Berkó, S.; Kovács, A.; Csányi, E. Combination of zinc hyaluronate and metronidazole in a lipid-based drug delivery system for the treatment of periodontitis. Pharmaceutics 2019, 11, 142. [Google Scholar] [CrossRef]
- Jankowski, A.; Dyja, R.; Sarecka-Hujar, B. Dermal and transdermal delivery of active substances from semisolid bases. Indian J. Pharm. Sci. 2017, 79, 488–500. [Google Scholar]
- Parhi, R. Cross-linked hydrogel for pharmaceutical applications: A review. Adv. Pharm. Bull. 2017, 7, 515–530. [Google Scholar] [CrossRef]
- Caló, E.; Khutoryanskiy, V.V. Biomedical applications of hydrogels: A review of patents and commercial products. Eur. Polym. J. 2015, 65, 252–267. [Google Scholar] [CrossRef]
- Davidovich-Pinhas, M. Oleogels: A promising tool for delivery of hydrophobic bioactive molecules. Ther. Deliv. 2016, 7, 1–3. [Google Scholar] [CrossRef]
- Shakeela, A.; Farooqa, U.; Iqbala, T.; Yasina, S.; Lupic, F.R.; Gabriele, D. Key characteristics and modelling of bigels systems: A review. Mater. Sci. Eng. C 2019, 97, 932–953. [Google Scholar] [CrossRef]
- Dione, N.; Khelaifia, S.; Lagier, J.C.; Ra, D. The aerobic activity of metronidazole against anaerobic bacteria. Int. J. Antimicrob. Agents 2015, 45, 537–540. [Google Scholar] [CrossRef]
- Junmahasathien, T.; Panraksa, P.; Protiarn, P.; Hormdee, D.; Noisombut, R.; Kantrong, N.; Jantrawut, P. Preparation and evaluation of metronidazole-loaded pectin films for potentially targeting a microbial infection associated with periodontal disease. Polymers 2018, 10, 1021. [Google Scholar] [CrossRef]
- Al-Sayed Sallam, A.-S.; Hamudi, F.F.; Khalil, E.A. Effect of ethylcellulose and propylene glycol on the controlled-release performance of glyceryl monooleate-mertronidazole periodontal gel. Pharm. Dev. Technol. 2015, 20, 159–168. [Google Scholar] [CrossRef]
- Rediguieri, C.F.; Porta, V.G.; Nunes, D.S.; Nunes, T.M.; Junginger, H.E.; Kopp, S.; Midha, K.K.; Shah, V.P.; Stavchansky, S.; Dressman, J.B.; et al. Biowaiver monographs for immediate release solid oral dosage forms: Metronidazole. J. Pharm. Sci. 2011, 100, 1618–1627. [Google Scholar] [CrossRef]
- Yu, M.; Ma, H.; Lei, M.; Li, N.; Tan, F. In vitro/in vivo characterization of nanoemulsion formulation of metronidazole with improved skin targeting and anti-rosacea properties. Eur. J. Pharm. Biopharm. 2014, 88, 92–103. [Google Scholar] [CrossRef]
- Dua, K.; Malipeddi, V.R.; Madan, J.; Gupta, G.; Chakravarthi, S.; Awasthi, R.; Kikuchi, I.S.; De Jesus Andreoli Pinto, T. Norfloxacin and metronidazole topical formulations for effective treatment of bacterial infections and burn wounds. Interv. Med. Appl. Sci. 2016, 8, 68–76. [Google Scholar] [CrossRef] [PubMed]
- Szekalska, M.; Winnicka, K.; Czajkowska–Kośnik, A.; Sosnowska, K.; Amelian, A. Evaluation of alginate microspheres with metronidazole obtained by the spray drying technique. Acta Pol. Pharm. 2015, 72, 569–578. [Google Scholar] [PubMed]
- Wróblewska, M.; Winnicka, K. The effect of cationic polyamidoamine dendrimers on physicochemical characteristics of hydrogels with erythromycin. Int. J. Mol. Sci. 2015, 16, 20277–20289. [Google Scholar] [CrossRef] [PubMed]
- The European Pharmacopoeia 8.0; Council of Europe: Strasbourg, France, 2014.
- Tomczykowa, M.; Wróblewska, M.; Winnicka, K.; Wieczorek, P.; Majewski, P.; Celińska-Janowicz, K.; Sawczuk, R.; Miltyk, W.; Tryniszewska, E.; Tomczyk, M. Novel gel formulations as topical carriers for the essential oil of Bidens tripartita for the treatment of candidiasis. Molecules 2018, 23, 2517. [Google Scholar] [CrossRef]
- Hurler, J.; Engesland, A.; Poorahmary Kermany, B.; Škalko-Basnet, N. Improved texture analysis for hydrogel characterization: Gel cohesiveness, adhesiveness, and hardness. J. Appl. Polym. Sci. 2012, 125, 180–188. [Google Scholar] [CrossRef]
- Carvalho, F.C.; Calixto, G.; Hatakeyama, I.N.; Luz, G.M.; Gremião, M.P.; Chorilli, M. Rheological, mechanical, and bioadhesive behavior of hydrogels to optimize skin delivery systems. Drug Dev. Ind. Pharm. 2013, 39, 1750–1757. [Google Scholar] [CrossRef]
- Wróblewska, M.; Szekalska, M.; Hafner, A.; Winnicka, K. Oleogels and bigels as topical drug carriers for ketoconazole—Development and in vitro characterization. Acta Pol. Pharm. 2018, 75, 777–786. [Google Scholar]
- Costa, P.; Sousa Lobo, J.M. Modeling and comparison of dissolution profiles. Eur. J. Pharm. Sci. 2001, 13, 123–133. [Google Scholar] [CrossRef]
- Zhang, Y.; Huo, M.; Zhou, J.; Zou, A.; Li, A.; Yao, C.; Xie, S. DDSolver: An add-in program for modeling and comparison of drug dissolution profiles. AAPS J. 2010, 12, 263–271. [Google Scholar] [CrossRef]
- Mateus, D.; Marto, J.; Trindade, P.; Gonçalves, H.; Salgado, A.; Machado, P.; Melo-Gouveia, A.; Ribeiro, H.M.; Almeida, A.J. Improved morphine-loaded hydrogels for wound-related pain relief. Pharmaceutics 2019, 11, 76. [Google Scholar] [CrossRef]
- Shanker, G.; Kumar, C.K.; Gonugunta, C.S.; Kumar, B.V.; Veerareddy, P.R. Formulation and evaluation of bioadhesive buccal drug delivery of tizanidine hydrochloride tablets. AAPS PharmSciTech 2009, 10, 530–539. [Google Scholar] [CrossRef] [PubMed]
- Muniz, B.V.; Baratelli, D.; Di Carla, S.; Serpe, L.; da Silva, C.B.; Guilherme, V.A.; Ribeiro, L.N.M.; Cereda, C.M.S.; de Paula, E.; Volpato, M.C.; et al. Hybrid hydrogel composed of polymeric nanocapsules co-loading lidocaine and prilocaine for topical intraoral anesthesia. Sci. Rep. 2018, 8, 17972. [Google Scholar] [CrossRef] [PubMed]
- Kobayashia, M.; Hattorib, Y.; Sasakic, T.; Otsuka, M. Effect of ball milling on the physicochemical properties of atorvastatin calcium sesquihydrate: The dissolution kinetic behaviours of milled amorphous solids. J. Pharm. Pharmacol. 2017, 69, 15–22. [Google Scholar] [CrossRef] [PubMed]
- Zheng, Y.; Fu, Z.; Li, D.; Wu, M. Effects of ball milling processes on the microstructure and rheological properties of microcrystalline cellulose as a sustainable polymer additive. Materials 2018, 11, 1057. [Google Scholar] [CrossRef] [PubMed]
- Gyles, D.A.; Castro, L.D.; Carréra Silva, J.O., Jr.; Ribeiro-Costa, R.M. A review of the designs and prominent biomedical advances of natural and synthetic hydrogel formulations. Eur. Polym. J. 2017, 88, 373–392. [Google Scholar] [CrossRef]
- Samala, M.; Sridevi, G. Role of polymers as gelling agents in the formulation of emulgels. Polym. Sci. 2016, 2, 1–8. [Google Scholar]
- Patel, A.R.; Mankoc, B.; Bin Sintang, M.D.; Lesafferb, A.; Dewettinck, K. Fumed silica-based organogels and ‘aqueousorganic’ bigels. RSC Adv. 2015, 5, 9703–9708. [Google Scholar] [CrossRef]
- Lu, Z.; Fassihi, R. Influence of colloidal silicon dioxide on gel strength, robustness, and adhesive properties of diclofenac gel formulation for topical application. AAPS PharmSciTech 2015, 16, 636–644. [Google Scholar] [CrossRef]
- Szekalska, M.; Puciłowska, A.; Szymańska, E.; Ciosek, P.; Winnicka, K. Alginate: Current use and future perspectives in pharmaceutical and biomedical applications. Int. J. Polym. Sci. 2016, 17, 1–17. [Google Scholar] [CrossRef]
- The United States Pharmacopeia, USP 41–NF 36; The United States Pharmacopeial Convention: Rockville, MD, USA, 2016.
- Wang, D.P.; Yeh, M.K. Degradation kinetics of metronidazole in solution. J. Pharm. Sci. 1993, 82, 95–98. [Google Scholar] [CrossRef]
- Shekunov, B.Y.; Chattopadhyay, P.; Tong, H.H.; Chow, A.H. Particle size analysis in pharmaceutics: Principles, methods and applications. Pharm. Res. 2007, 24, 203–227. [Google Scholar] [CrossRef] [PubMed]
- Palacio, M.L.; Bhushan, B. Bioadhesion: A review of concepts and applications. Philos. Trans. A Math. Phys. Eng. Sci. 2012, 370, 2321–2347. [Google Scholar] [CrossRef] [PubMed]
- Bassi da Silva, J.; Ferreira, S.B.S.; Reis, A.V.; Cook, M.T.; Bruschi, M.L. Assessing mucoadhesion in polymer gels: The effect of method type and instrument variables. Polymers 2018, 10, 3. [Google Scholar] [CrossRef] [PubMed]
- Singh, R.; Sharma, D.; Garg, R. Review on mucoadhesive drug delivery system with special emphasis on buccal route: An important tool in designing of novel controlled drug delivery system for the effective delivery of pharmaceuticals. J. Dev. Drugs. 2017, 6, 169. [Google Scholar]
- Aslani, A.; Malekpour, N. Design, formulation, and physicochemical evaluation of periodontal propolis mucoadhesive gel. Dent. Res. J. 2016, 13, 484–493. [Google Scholar] [CrossRef]
- Martinsa, A.J.; Silvaa, P.; Maciela, F.; Pastranab, L.M.; Lopes Cunhac, R.; Cerqueirab, M.A.; Vicentea, A.A. Hybrid gels: Influence of oleogel/hydrogel ratio on rheological and textural properties. Food Res. Int. 2019, 116, 1298–1305. [Google Scholar] [CrossRef]
- Menchicchi, B.; Fuenzalida, J.P.; Hensel, A.; Swamy, M.J.; David, L.; Rochas, C.; Goycoolea, F.M. Biophysical analysis of the molecular interactions between polysaccharides and mucin. Biomacromolecules 2015, 16, 924–935. [Google Scholar] [CrossRef]
- Franz-Montan, M.; Serpe, L.; Martinelli, C.C.; da Silva, C.B.; Santos, C.P.; Novaes, P.D.; Volpato, M.C.; de Paula, E.; Lopez, R.F.; Groppo, F.C. Evaluation of different pig oral mucosa sites as permeability barrier models for drug permeation studies. Eur. J. Pharm. Sci. 2016, 81, 52–59. [Google Scholar] [CrossRef]
- Dingsdag, S.A.; Hunter, N. Metronidazole: An update on metabolism, structure-cytotoxicity and resistance mechanisms. J. Antimicrob. Chemother. 2018, 73, 265–279. [Google Scholar] [CrossRef]
- Hernández Ceruelos, A.; Romero-Quezada, L.C.; Ruvalcaba Ledezma, J.C.; López Contreras, L. Therapeutic uses of metronidazole and its side effects: An update. Eur. Rev. Med. Pharmacol. Sci. 2019, 23, 397–401. [Google Scholar]

| Ingredient (g) | Hydrogels (H) | Oleogels (O) | Bigels (B) (H+O 70:30) | ||||||
|---|---|---|---|---|---|---|---|---|---|
| H | HMET | HMMET | O | OMET | OMMET | B | BMET | BMMET | |
| MET | - | 10.0 | - | - | 10.0 | - | - | 10.0 | - |
| MMET | - | - | 10.0 | - | - | 10.0 | - | - | 10.0 |
| Aerosil®200 | - | - | - | 5.0 | 5.0 | 5.0 | 1.5 | 1.5 | 1.5 |
| Tween 80 | - | - | - | 1.0 | 1.0 | 1.0 | 0.3 | 0.3 | 0.3 |
| Tocopheryl acetate | - | - | - | 0.05 | 0.05 | 0.05 | 0.05 | 0.05 | 0.05 |
| Linseed oil | - | - | - | up to 100.0 | up to 100.0 | up to 100.0 | up to 30.0 | up to 30.0 | up to 30.0 |
| Sodium alginate | 1.75 | 1.75 | 1.75 | - | - | - | 1.23 | 1.23 | 1.23 |
| Glycerol 85% | 20.0 | 20.0 | 20.0 | - | - | - | 14.0 | 14.0 | 14.0 |
| Ethyl alcohol 96% | 10.0 | 10.0 | 10.0 | - | - | - | 7.0 | 7.0 | 7.0 |
| Methyl paraben | 0.2 | 0.2 | 0.2 | - | - | - | 0.2 | 0.2 | 0.2 |
| Propyl paraben | 0.02 | 0.02 | 0.02 | - | - | - | 0.02 | 0.02 | 0.02 |
| Purified water | up to 100 | up to 100 | up to 100 | - | - | - | up to 70.0 | up to 70.0 | up to 70.0 |
| Ball Milling Parameters | Solubility in Water (mg/mL) | Solubility in Phosphate Buffer pH 6.8 (mg/mL) | Solubility in Linseed Oil (mg/mL) | Particles Size (µm) |
|---|---|---|---|---|
| - | 7.98 ± 1.65 | 6.91 ± 3.08 | 0.363 ± 7.34 | 334.6 ± 384.6 |
| 5 min/20 Hz | 8.52 ± 2.18 | 6.91 ± 1.50 | 0.382 ± 6.89 | 33.9 ± 33.6 |
| 10 min/20 Hz | 8.77 ± 3.78 | 7.39 ± 2.58 | 0.408 ± 3.19 | 15.2 ± 6.4 |
| 20 min/20 Hz | 8.92 ± 3.05 | 7.49 ± 2.69 | 0.444 ± 4.56 | 10.7 ± 3.9 |
| 30 min/20 Hz | 10.00 ± 2.22 | 8.29 ± 2.78 | 0.445 ± 6.98 | 10.7 ± 3.8 |
| 60 min/20 Hz | 10.04 ± 1.60 | 9.03 ± 3.09 | 0.445 ± 9.24 | 10.4 ± 4.1 |
| Formulation Code | Drug Content (%) | pH | Particles Size (µm) | Viscosity * (mPa∙s) |
|---|---|---|---|---|
| C | 100.8 ± 0.3 | 9.5 ± 0.02 | 74.7 ± 31.4 | 12,621 ± 147 |
| H | - | 9.5 ± 0.01 | - | 6542 ± 61 |
| HMET | 102.0 ± 6.4 | 8.9 ± 0.01 | 138.4 ± 66.7 | 8563 ± 73 |
| HMMET | 99.9 ± 1.0 | 8.6 ± 0.02 | 18.9 ± 8.7 | 7660 ± 42 |
| O | - | 5.9 ± 0.02 | - | 2798 ± 20 |
| OMET | 92.3 ± 2.3 | 6.4 ± 0.01 | 101.1 ± 67.4 | 10,769 ± 98 |
| OMMET | 95.4 ± 0.2 | 6.0 ± 0.01 | 18.5 ± 8.5 | 9267 ± 32 |
| B | - | 9.0 ± 0.02 | - | 13,236 ± 182 |
| BMET | 98.6 ± 2.2 | 8.5 ± 0.01 | 103.3 ± 41.4 | 16,279 ± 148 |
| BMMET | 97.6 ± 3.9 | 8.1 ± 0.01 | 18.6 ± 9.2 | 14,220 ± 60 |
| Formulation Code | Firmness (g) | Compressibility (g·s) | Adhesiveness (g·s) |
|---|---|---|---|
| C | 247.0 ± 16.8 | 267.3 ± 26.0 | −352.6 ± 16.9 |
| H | 54.7 ± 3.0 | 110.0 ± 4.8 | −135.6 ± 2.4 |
| HMET | 55.2 ± 3.9 | 113.6 ± 7.3 | −139.3 ± 8.1 |
| HMMET | 55.0 ± 4.4 | 110.2 ± 3.6 | −137.3 ± 6.5 |
| O | 25.7 ± 0.5 | 55.5 ± 0.8 | −58.8 ± 0.7 |
| OMET | 251.6 ± 2.6 | 386.5 ± 23.3 | −369.0 ± 35.7 |
| OMMET | 229.3 ± 6.8 | 326.1 ± 4.1 | −344.6 ± 23.5 |
| B | 112.5 ± 8.3 | 214.8 ± 17.8 | −248.2 ± 17.0 |
| BMET | 136.6 ± 11.7 | 251.1 ± 29.5 | −315.8 ± 15.5 |
| BMMET | 127.5 ± 2.7 | 240.7 ± 6.7 | −273.6 ± 5.8 |
| Formulation Code | Kinetic Models | ||||||||
|---|---|---|---|---|---|---|---|---|---|
| Zero Order Kinetics | First Order Kinetics | Higuchi Model | Korsmeyer–Peppas Model | ||||||
| R2 | K0 | R2 | KI | R2 | KH | R2 | KKP | n | |
| C | 0.961 | 9.257 | 0.985 | 0.130 | 0.998 | 26.012 | 0.908 | 0.484 | 0.607 |
| HMET | 0.980 | 5.428 | 0.988 | 0.092 | 0.999 | 19.555 | 0.953 | 0.722 | 0.472 |
| HMMET | 0.979 | 7.078 | 0.993 | 0.102 | 0.998 | 20.942 | 0.935 | 0.730 | 0.481 |
| OMET | 0.981 | 0.301 | 0.986 | 0.003 | 0.992 | 0.827 | 0.988 | 0.604 | 0.334 |
| OMMET | 0.969 | 0.547 | 0.970 | 0.006 | 0.999 | 1.532 | 0.960 | 0.673 | 0.374 |
| BMET | 0.969 | 6.989 | 0.985 | 0.067 | 0.998 | 15.061 | 0.946 | 0.682 | 0.454 |
| BMMET | 0.959 | 7.037 | 0.979 | 0.094 | 0.998 | 19.797 | 0.951 | 0.721 | 0.472 |
| Zone of Inhibition (mm) | Name of the Strain | |
|---|---|---|
| S. aureus ATCC 29213 | E. coli ATCC 25922 | |
| C | 18.7 ± 0.6 | 20.7 ± 0.6 |
| MET | 21.7 ± 1.2 | 22.0 ± 0.0 |
| MMET | 22.3 ± 0.6 | 24.3 ± 0.6 |
| H | 0.0 ± 0.0 | 0.0 ± 0.0 |
| HMET | 21.0 ± 1.0 | 22.3 ± 0.6 |
| HMMET | 21.7 ± 0.6 | 24.0 ± 0.0 |
| O | 0.0 ± 0.0 | 0.0 ± 0.0 |
| OMET | 8.0 ± 0.0 | 13.3 ± 1.5 |
| OMMET | 9.3 ± 1.2 | 15.0 ± 1.0 |
| B | 0.0 ± 0.0 | 0.0 ± 0.0 |
| BMET | 18.7 ± 1.2 | 21.0 ± 0.0 |
| BMMET | 19.3 ± 1.2 | 22.7 ± 1.2 |
© 2020 by the authors. Licensee MDPI, Basel, Switzerland. This article is an open access article distributed under the terms and conditions of the Creative Commons Attribution (CC BY) license (http://creativecommons.org/licenses/by/4.0/).
Share and Cite
Wróblewska, M.; Szymańska, E.; Szekalska, M.; Winnicka, K. Different Types of Gel Carriers as Metronidazole Delivery Systems to the Oral Mucosa. Polymers 2020, 12, 680. https://doi.org/10.3390/polym12030680
Wróblewska M, Szymańska E, Szekalska M, Winnicka K. Different Types of Gel Carriers as Metronidazole Delivery Systems to the Oral Mucosa. Polymers. 2020; 12(3):680. https://doi.org/10.3390/polym12030680
Chicago/Turabian StyleWróblewska, Magdalena, Emilia Szymańska, Marta Szekalska, and Katarzyna Winnicka. 2020. "Different Types of Gel Carriers as Metronidazole Delivery Systems to the Oral Mucosa" Polymers 12, no. 3: 680. https://doi.org/10.3390/polym12030680
APA StyleWróblewska, M., Szymańska, E., Szekalska, M., & Winnicka, K. (2020). Different Types of Gel Carriers as Metronidazole Delivery Systems to the Oral Mucosa. Polymers, 12(3), 680. https://doi.org/10.3390/polym12030680

